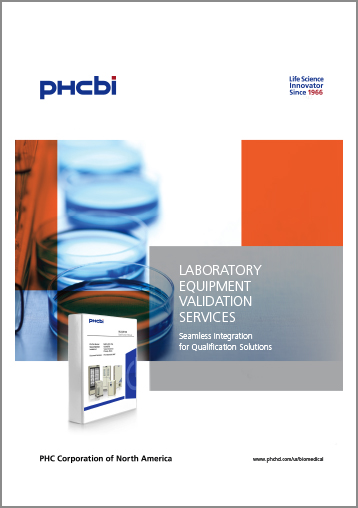

Laboratory Equipment Validation Services
Seamless Integration for Qualification Services
Our services simplify the entire validation process and reduce setup time with minimal sensor handling, automated sensor calibration, systemically organized study data and regulatory report generation.
Download the Brochure